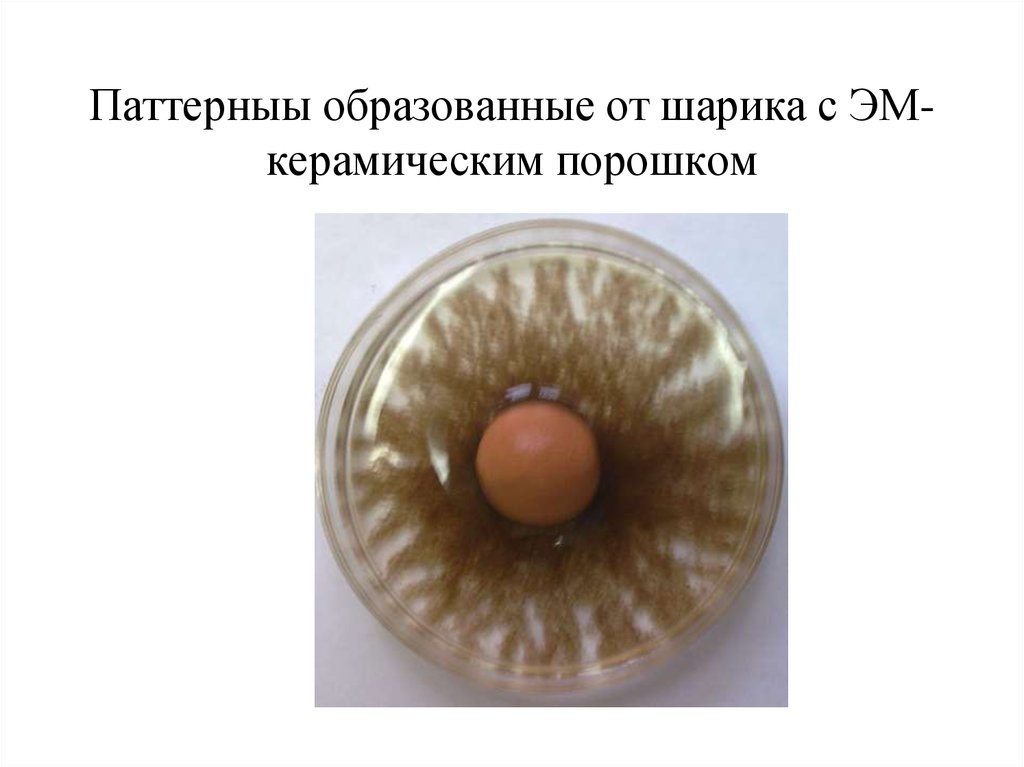
Паттерныы образованные от шарика с ЭМ-керамическим порошком

Similar presentations:
Паттерны микроорганизмов
1. ПАТТЕРНЫ МИКРООРГАНИЗМОВ И АЯ Симаков Ю.Г. МГУ ТУ имени К.Г.Разумовского, Москва, Россия, usimakov@yandex.ru CONCEPT
ПАТТЕРНЫ МИКРООРГАНИЗМОВ И АЯСимаков Ю.Г.
МГУ ТУ имени К.Г.Разумовского, Москва,
Россия, usimakov@yandex.ru
CONCEPT VIOLATIONS OF INFORMATION
COMMUNICATION IN TEST-OBJECTS
Simakov Yu.G.
2. ВИДЫ ПАТТЕРНОВ У ТЕСТ ОБЪЕКТОВ
№п/п
Тест- объект
Вид паттерна
1
Хламидомонада
2
Сценедесмус
Дендровиднык
фракталы
« Спицы колеса»
з
Нефрохдорис
Полосы
4
Политома
5
Бактериальные
зооглеи биофильтра
Копулирующие
пары
Дендровидные
фракталы
3. ПАТТЕРНЫ ХЛАМИДОМОНАД Chlamydomonas smithii
• Паттерны втоксичной среде
зависят от формы
сосуда
4.
5. РАСПРЕДЕЛЕНИЕ САПРОФИТНЫХ БАКТЕРИЙ В ЧАШКЕ ПЕТРИ
6. КОНТРОЛЬ С ПОМЕЩЕНИЕМ ПРЕДМЕТА В ЧАШКУ ПЕТРИ
• МЕТАЛЛИЧЕСКАЯШАЙБА И
ПЛАСТМАССОВЫЕ
КУБИКИ НЕ
НАРУШАЮТ
РАСПРДЕЛЕНИЯ
БАКТЕРИЙ В ЧАШКЕ
ПЕТРИ
7. ЗАЦЕМЕНТИРОВАННАЯ КРОВЬ И ПАТТЕРНЫ ЗООГЛЕЙ
Зацементированнаякровь в стеклянной
ампуле из БАТ R2
приводит к
образованию
паттернов
сапрофитными
бактерими
8. ПАТТЕРНЫ ЗООГЛЕЙ ПОД ВЛИЯНИЕМ ЗАМУРОВАННЫХ БАКТЕРИЙ
• Цементный кубикбез бактерий
9. Зуб и паттерны спрофитных бактерий в чашке Петри
• Зуб помещенныйв центр чашки
Петри с
бактериями
способствует
образованию
специфического
паттерна
10. ПАТТЕРНЫ СЦЕНЕДЕСМУСА ОБРАЗУЮТСЯ ПРИ НАЛИЧИИ зацементированных микроорганизмов
Слева-контроль. В чашке Петри через 15 минутпосле контакта с цементным кубиком с
зацементированными микроорганизами .
11. ФРАГМЕНТ ФРАКТАЛА ОБРАЗОВАННЫЙ НЕФРОХЛОРИСОМ
КонтрольОпыт
Nephrochloris salina. Аутотаксис у водоросли
повышается ПРИ появлении плазмоидов.
12. МЕЖКЛЕТОЧНЫЕ ВЗАИМОДЕЙСТВИЯ У ПОЛИТОМ В ТОКСИЧНОЙ СРЕДЕ
КонцК.
10
1,0
Пар
%
100
29±
5,1
70*± 108±
8.1
7,2
0,1
Количество пар гамет в Na2S
Polytoma uvella (EC50= 1,2 мг/л))
Polytoma uvella
Конц К. 75
.
Выж 97 52 ±
. (%)
8,4
10
1,0
80±
7,7
93
±6,8
Выживаемость Daphnia magna в Na2S
(LC50=75 мг/л))
13. Паттерныы образованные от шарика с ЭМ-керамическим порошком
Паттерныы образованные от шарика с ЭМкерамическим порошком14. ПАТТЕРНЫ БАКТЕРИАЛЬНЫХ ЗООГЛЕЙ В ТОКСИЧНОЙ ВОДНОЙ СРЕДЕ
КонтрольОпыт (азотол 1,0 мг/л)
15. СРАВНИТЕЛЬНЫЕ МОДЕЛЬНЫЕ ОПЫТЫ
Биотестетирование по выживаемости дафниМг/л
Конт.
75
10
1,0
Na2 S
96,6
52± 8,4
80*±7,7
93 ±7,8
ZnSO4
96.6
65±6,6
83*±5.2
96±4.8
Азот.
96,6
60.±5,7
78*±6,4
96±5,7
По нарушению аутотаксиса у хламидомонад
Мг/л
Конт.
10
1,0
0,1
Фракт.
+
-
+++
+
16. ПРЕИМУЩЕСТВО БИОТЕСТИРОВАНИЯ ПО НАРУШЕНИЮ ИНФОРМАЦИОННЫХ СВЯЗЕЙ
• Тесты относятся к экспресс- методам(выполняются 1-60 минут)
• Они могут выполняться в полевых
условиях с минимумом аппаратуры
• В основу токсического показателя
заложена EC (+ -), а не LC 50
• Тесты по аутотаксисам часто в 10 раз
чувствительнее тестов по выживаемости

biology
biology








